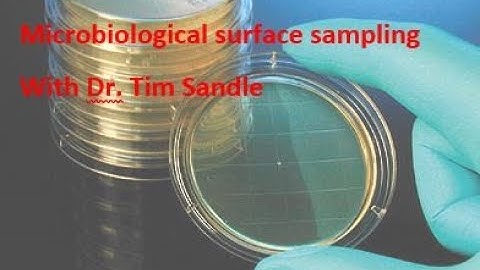
Microbiological environmental surface sampling using an agar contact plate

⬇ DOWNLOAD NOW
Kalau muncul iklan pop-up, tutup lalu klik tombol kembali
Download lagu How to: USP 797 guidelines: Sample Contact Plate Samples secara gratis hanya untuk keperluan promosi. Dukung artis favorit kamu dengan membeli musik original di iTunes atau platform resmi lainnya.
 Environmental Surface Sampling Using Contact Agar Plates
Environmental Surface Sampling Using Contact Agar Plates
 Environmental Surface Sampling with Agar Plates
Environmental Surface Sampling with Agar Plates
 USP 797 Testing Services by EMSL Analytical, Inc.
USP 797 Testing Services by EMSL Analytical, Inc.
 Gloved Fingertip Sampling Using Agar Plates
Gloved Fingertip Sampling Using Agar Plates
 Understanding USP 797 Microbiology Testing Requirements
Understanding USP 797 Microbiology Testing Requirements
 Surface Wipe Sampling Technique
Surface Wipe Sampling Technique
Microbiological environmental surface sampling using an agar contact plate
Microbiological environmental surface sampling using an agar contact plate
 Water Activity | USP 795 & 797 Revisions
Water Activity | USP 795 & 797 Revisions